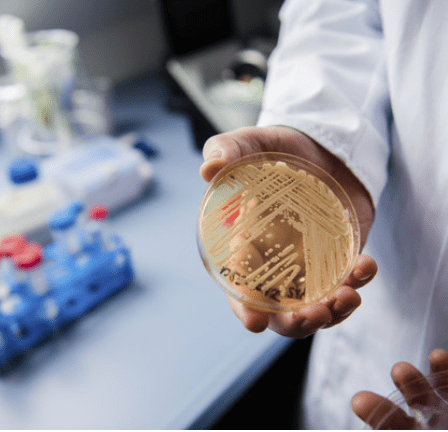
新加坡连续两周新冠确诊病例破万！美国也出事了？！

在新加坡确诊新冠怎么办?


ART检测阳性的无症状感染者
需要立刻做的事:自我隔离72小时后再做一次抗原快速检测,并时刻观察自己的身体状况
可以获取的帮助:不需要特别帮助,只需要使用政府发放的ART检测仪做检测
家庭活动:整户应尽量减少活动;家人不需要隔离
下一步应做的事:观察72小时,期间如果出现症状要做PCR检测
何时算做康复:72小时后ART检测阴性即代表已经康复,之后不需要做PCR检测
ART检测阳性的有症状感染者
需要立刻做的事:立即进行PCR检测确定是否真的得病。情况如果变得严重立即去寻求医疗援助。
可以获取的帮助:可以在拭子检测计划(SASH)诊所或共卫生预备诊所(PHPC)做免费PCR检测
家庭活动:整户应尽量减少活动。除非PCR检测结果也是阳性,否则家人不需要隔离。
下一步应做的事:等待PCR检测结果前自我隔离
何时算做康复:PCR结果呈阴性,之后应继续观察自己的身体状况
PCR检测阳性的无症状或轻症感染者
需要立刻做的事:查看自己是否能在家里隔离,并在保护家人安全的同时自我恢复
可以获取的帮助:如果可以在家隔离恢复,卫生部会派遣一名居家康复伙伴、一份居家康复关怀礼包(包括温度计、血氧仪、口罩和洗手液),和全天候远程医疗服务;如果无法在家隔离,会在社区康复中心或医院进行恢复
家庭活动:家人需要注册电子隔离令,并在诊所或检测中心做拭子检测;领取自助抗原检测仪并隔离10天,根据隔离要求做ART检测
下一步应做的事:如果可以居家康复,保持隔离10天,密切关注症状并做ART检测
何时算做康复:10天之后自我感觉良好,之后不必再做PCR检测
PCR检测阳性的重症感染者
需要立刻做的事:立即寻找医疗援助
可以获取的帮助:在社区康复中心或医院进行恢复
家庭活动:家人需要注册电子隔离令,并在诊所或检测中心做拭子检测;领取自助抗原检测仪并隔离10天,根据隔离要求做ART检测
下一步应做的事:接受医院的治疗
何时算做康复:从社区康复中心或医院出院



3,没有收到关怀礼包,应该通知谁?

5,关怀礼包里面最重要的是血氧仪
6,隔离过程中出现症状,或者症状恶化
7,我的同住者怎么办?

8,如果家人确诊,怎么办?他们也可以在家康复吗?
9,我和同住者不能出门,怎么买食物和日常用品
10,我的自助检测仪ART要用完了,应该联络谁?